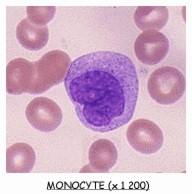

Processus immunitaires
LES PROCESSUS IMMUNITAIRES MIS EN JEU
1 Les anticorps, agents du maintien de l'intégrité du milieu extra-cellulaire
La séropositivité pour le VIH correspond à la présence d'anticorps spécifiques contre certaines protéines du virus. La synthèse d'anticorps est la signature d'une réaction de l'organisme à la présence d'éléments étrangers. Les anticorps agissent dans le milieu extracellulaire en se liant spécifiquement aux antigènes qui ont déclenché leur formation.
Recherchons ce qui, dans la structure d'un anticorps, explique sa capacité à se lier spécifiquement à un antigène.
1.1 LA REACTION ANTIGENE-ANTICORPS
1.1.1 Mise en évidence d'anticorps dans le sang par électrophorèse
Comparons la composition protéique du sérum d'un lapin ayant reçu par injection une molécule étrangère, l'albumine de boeuf (lapin immunisé) et celle d'un lapin témoin non immunisé par la technique d'électrophorèse.
![]()
![]() La manipulation doit être réalisée en respectant les protocoles fournis avec le matériel. En voici les principales phases:
La manipulation doit être réalisée en respectant les protocoles fournis avec le matériel. En voici les principales phases:
1 - Remplissez les deux compartiments de la cuve avec du tampon tri-phosphate à pH 9,2.
2 - Trempez deux bandes d'acétate de cellulose dans la même solution tampon pendant 10 min. 3 - Fixez ces deux bandes sur le portoir, le sérum côté cathode. Appliquez à l'aide de l'applicateur une micro-goutte de sérum à 15 mm du bord de la première bande, recommencez la même opération pour la deuxième bande.
3 - Fixez ces deux bandes sur le portoir, le sérum côté cathode. Appliquez à l'aide de l'applicateur une micro-goutte de sérum à 15 mm du bord de la première bande, recommencez la même opération pour la deuxième bande.
4 - Laissez migrer les protéines sériques pendant une heure.
5 - Retirez les bandes et les immerger dans une solution de Rouge Ponceau pendant 10 min.
6 - Rincez les bandes dans trois bains successifs d'acide éthanoïque à 5% pendant 5 min.
7 - Laissez sécher. Observez.
8 - Les bandes peuvent être numérisée avec un scanner et les photographies traitées par le logiciel MESURIM pour être transformées en profil électrophorétique.
Rappelez le principe sur lequel repose la séparation des protéines dans une électrophorèse. Analysez les deux électrophorégrammes et les deux profils électrophorétiques (chez le lapin on trouve respectivement les protéines gamma-, bêta- et alpha-globulines et les albumines dans le sens de migration).
Expliquez en quoi la sécrétion d'anticorps correspond à une immunité acquise par un processus actf.

1.1.2 Le test d'Ouchterlony
Dans cette méthode, antigène et anticorps, introduits séparément, diffusent dans un gel d'agarose et à leur rencontre se produit une réaction qui peut être visualisée.
![]()
![]() Le fond de deux boîtes de Pétri contient un gel d'agarose dans lequel ont été réalisés 6 puits périphériques et un puits central (voir le document) à égale distance les uns des autres.
Le fond de deux boîtes de Pétri contient un gel d'agarose dans lequel ont été réalisés 6 puits périphériques et un puits central (voir le document) à égale distance les uns des autres.
Dans chacun des puits périphériques on a déposé, en égal volume, différentes solutions d'antigènes:
 Puits 1: de l'albumine sérique de bœuf (ASB),
Puits 1: de l'albumine sérique de bœuf (ASB),
Puits 2: du sérum de cheval,
Puits 3: du sérum de lapin,
Puits 4: du sérum de porc,
Puits 5: du sérum de bœuf,
Puits 6: du sérum de chèvre.
Dans le puits central de la boîte à gauche on a déposé une solution d'anticorps anti-ASB (sérum de lapin immunisé contre l'albumine sérique de bœuf).
Dans le puits central de la boîte à droite on a déposé du sérum de lapin non immunisé contre l'albumine sérique de bœuf.
Les boîtes sont fermées et conservées à température ambiante pendant 24 heures: les produits de chaque puits diffusent dans le gel. On peut traiter chacune des deux boîtes par un colorant, le bleu de Coomasie, qui souligne la réaction qui s'est produite entre certains puits.
Qu'observez-vous? Comment interprétez-vous les faits entre certains puits et l'absence de réaction entre d'autres puits?
Quelle caractéristique fondamentale de la réaction Ac-Ag ressort-il de cette expérience?
1.2 MECANISMES MOLECULAIRES
 1.2.1 Modélisation moléculaire des anticorps ou immunoglobulines:
1.2.1 Modélisation moléculaire des anticorps ou immunoglobulines:
Il est possible de comprendre la structure tridimensionnelle d'une molécule d'anticorps - encore appelée immunoglobuline - en la visualisant grâce aux logiciels RASMOL ou CHIME, que l'on trouvera sur le site de l'INRP.
La forme en Y de l'anticorps correspond à l'assemblage de quatre chaînes polypeptidiques enroulées et interconnectées, identiques deux à deux: deux chaînes lourdes et deux chaînes légères.
1.2.2 Séquences peptidiques d'une molécule d'anticorps:
On pourra trouver à l'adresse http://www.inrp.fr/Acces/biotic/immuno/html/demigg.htm toutes les ressources destinées à résoudre le problème biologique suivant:
Qu'est-ce qui, dans la structure d'un anticorps, explique sa capacité à se lier spécifiquement à un antigène?
Notamment on peut proposer de comparer, à l'aide du logiciel ANAGENE, les séquences peptidiques de différents anticorps.
![]()
![]() 1 - Pour ce faire, vous commencerez par télécharger le fichier "igg-vih-8seq.edi" dans la page "Téléchargements" -> rubrique "Données moléculaires - Séquences pour Anagène".
1 - Pour ce faire, vous commencerez par télécharger le fichier "igg-vih-8seq.edi" dans la page "Téléchargements" -> rubrique "Données moléculaires - Séquences pour Anagène".
2 - Vous trouverez à la page "Ressources" -> rubrique "Données - Séquences" le contenu des huit séquences de ce fichier.
3 - Vous introduirez ce fichier dans la banque personnelle d'ANAGENE.
4 - L'exploitation pourra être conduite en comparant:
- les chaines lourdes entre elles,
- les chaînes légères entre elles.
A quelles conclusions importantes parvenez-vous?
Toujours à la même adresse il sera possible, à l'aide du logiciel RASTOP, de préciser l'étude de la structure tridimensionnelle des branches du Y d'un anticorps.
![]()
![]() Après avoir procédé à une coloration sélective des acides aminés 1 à 110 des chaines légères et 1 à 120 des chaînes lourdes, dont vous pouvez voir le résultat à la page "Localisation, sur les molécules en 3D, des régions variables des chaînes lourdes et légères", quelle information est apportée par cette coloration?
Après avoir procédé à une coloration sélective des acides aminés 1 à 110 des chaines légères et 1 à 120 des chaînes lourdes, dont vous pouvez voir le résultat à la page "Localisation, sur les molécules en 3D, des régions variables des chaînes lourdes et légères", quelle information est apportée par cette coloration?
1.2.3 Modèle moléculaire simple d'un anticorps:
 La structure simplifiée d'une molécule d'anticorps est schématisée sur la figure ci-contre à gauche. Les deux chaînes "lourdes" ont une masse molaire comprise entre 40 000 et 70 000, les deux chaînes légères, elles, ont une masse molaire de 22 500.
La structure simplifiée d'une molécule d'anticorps est schématisée sur la figure ci-contre à gauche. Les deux chaînes "lourdes" ont une masse molaire comprise entre 40 000 et 70 000, les deux chaînes légères, elles, ont une masse molaire de 22 500.
Chaque chaîne comporte une région variable (environ la moitié de la chaîne légère et un quart de la chaîne lourde) et une région constante. Ce sont les régions variables des chaînes légères et lourdes qui se replient dans l'espace pour former les sites de combinaison anticorps-antigène, c'est à dire les sites qui se lient aux antigènes particuliers contre lesquels les anticorps sont dirigés.
![]() Quelle explication pouvez-vous donner à l'existence de régions variables dans la molécule d'immunoglobuline?
Quelle explication pouvez-vous donner à l'existence de régions variables dans la molécule d'immunoglobuline?
Elaborez, à l'aide du schéma d'un antigène (Ag), que vous concevrez à la suite de l'étude ci-dessus, et de celui d'un anticorps (Ac) qui vous est proposé ci-contre et que vous simplifierez, une représentation d'un complexe Ag-Ac.
1.2.4 Modélisation d'un complexe antigène - anticorps (complexe immun)
Le même logiciel RASTOP vous permettra de vérifier la réalité en 3D d'un complexe Ag-Ac que vous venez de représenter.
1.3 ELIMINATION DES COMPLEXES IMMUNS: LA PHAGOCYTOSE
1.3.1 Une ligne de défense innée, non spécifique:
La phagocytose est un mécanisme cellulaire par lequel certaines cellules, les phagocytes, ingèrent puis dégradent par digestion intracellulaire des éléments solides capturés dans le milieu extracellulaire comme des bactéries ou d'autres cellules. Elle constitue une ligne de défense non spécifique qui se déroule en n'importe quel endroit de l'organisme,
Les macrophages sont des phagocytes. Ils ont pour origine des monocytes sanguins nés dans la moelle osseuse et qui gagnent les tissus lymphoïdes périphériques.
Les macrophages sont des phagocytes. Ils ont pour origine des monocytes sanguins nés dans la moelle osseuse et qui gagnent les tissus lymphoïdes périphériques. 
Lors de la phagocytose, les macrophages accolent leur membrane aux particules étrangères (1) puis les font pénétrer dans leur cytoplasme (2) à l'intérieur de vésicules membranaires (endocytose) où elles sont dégradées par digestion intracellulaire: des lysosomes issus de l'appareil de Golgi et contenant des enzymes lytiques déversent leur contenu dans les vésicules d'endocytose (3) pour former un phagosome (4).
Les déchets solides sont ensuite éliminés par exocytose (5).
La figure ci-contre présente de façon générale le mécanisme de la phagocytose.
1.3.2 Une aide à la phagocytose apportée par les anticorps
La phagocytose est également impliquée dans les réponses spécifiques lorsqu'elle est réalisée par certains phagocytes situés dans les organes lymphoïdes périphériques.
Dans ce cas, après que des immunoglobulines (anticorps) se furent fixés sur les antigènes de la paroi bactérienne, grâce à leur site de reconnaissance antigénique (complexes immuns), le bras Fc (fragment constant) de chaque anticorps est libre. Or la membrane plasmique des cellules phagocytaires porte des récepteurs membranaires capables de se fixer à ces fragments Fc: l'adhérence entre le phagocyte et la particule à ingérer est donc facilitée, et par là-même la phagocytose.
Ainsi, un mécanisme non spécifique, la phagocytose, qui est répandu chez de nombreuses cellules, est utilisé dans les organes lymphoïdes secondaires au cours de réactions immunitaires spécifiques faisant intervenir des anticorps.
C'est donc la phagocytose qui assure l'élimination des complexes immuns.
![]() Montrez que l'expression selon laquelle la phagocytose est une réaction immunitaire innée, non spécifique (vous définirez ces termes) doit être nuancée.
Montrez que l'expression selon laquelle la phagocytose est une réaction immunitaire innée, non spécifique (vous définirez ces termes) doit être nuancée.
1.4 ORIGINE DES ANTICORPS
 1.4.1 Les plasmocytes, cellules sécrétrices d'anticorps
1.4.1 Les plasmocytes, cellules sécrétrices d'anticorps
Les anticorps sont sécrétés dans le sang par de gros globules blancs spécialisés: les plasmocytes. Chaque plasmocyte ne sécrète qu'un seul type de molécule d'immuno-globulines.

![]()
![]() Après avoir réalisé un dessin d'observation de l'électronographie d'un plasmocyte, vous indiquerez, dans les annotations, les caractéristiques qui en font une cellule ayant une activité sécrétoire intense.
Après avoir réalisé un dessin d'observation de l'électronographie d'un plasmocyte, vous indiquerez, dans les annotations, les caractéristiques qui en font une cellule ayant une activité sécrétoire intense.
1.4.2 La production massive d'anticorps
La production d'anticorps en réponse à l'entrée d'un antigène dans l'organisme est le résultat de mécanismes complexes qui se déroulent en plusieurs étapes:
Reconnaissance de l'antigène et sélection clonale des lymphocytes B :
 Les différentes molécules d'anticorps présentes à la surface des lymphocytes B (LB) sont toutes identiques et reconnaissent le même antigène.
Les différentes molécules d'anticorps présentes à la surface des lymphocytes B (LB) sont toutes identiques et reconnaissent le même antigène.
Présents à raison de quelques milliers dans l'organisme, un groupe de lymphocytes B reconnaissant un antigène donné constitue un clone.
L'organisme est capable de reconnaître un très grand nombre d'antigènes différents: l'organisme contient donc autant de clones différents de lymphocytes B que d'antigènes susceptibles d'être reconnus.
Prolifération clonale des lymphocytes B activés:
L'activation d'un clone de lymphocytes B identiques se traduit par leur multiplication intense par mitoses (amplification ou prolifération clonale).
Différenciation en plasmocytes sécréteurs d'anticorps spécifiques:
Une partie de ces lymphocytes B se différencie en plasmocytes, une autre en lymphocytes B mémoire: ce sont des cellules à durée de vie longue, plus nombreuses que les LB initiaux spécifiques de l'antigène.
En résumé, les lymphocytes B, grâce à leurs anticorps membranaires, détectent des antigènes dans les liquides circulants.
Pour revenir au cas du SIDA, les anticorps dirigés contre les protéines virales peuvent bloquer la pénétration des virus dans les cellules, mais ne peuvent pas agir sur les cellules déjà infectées.
2 Les lymphocytes cyto-toxiques T8, agents du maintien des populations cellulaires
L'organisme dispose d'autres moyens de défense que les anticorps pour se débarasser d'un intrus: les lymphocytes T "tueurs" ou cytotoxiques peuvent détruire toute cellule anormale (cellule infectée par un virus, cellule cancéreuse, par exemple). Voyons comment ces lymphocytes T reconnaissent leur cible et la détruisent.
2.1 MODALITES DE DETECTION DES CELLULES ANORMALES PAR LES LT:
2.1.1 Expérience de Zinkernagel:
Il opère sur des souris appartenant toutes à une même souche A. Chez une souris de cette souche A, il introduit le virus LCM, pathogène, qui infecte les cellules nerveuses en déterminant une maladie: la chorioméningite, mais sans provoquer la mort de l'animal.
Sept jours plus tard, il teste les lymphocytes T (LT) prélevés dans la rate de cette souris immunisée en les transférant dans trois milieux de culture différents.
Les résultats sont fournis ci-dessous:
|
Milieu 1 |
90% des cellules sont lysées |
|
Milieu 2 |
Aucune cellule lysée |
|
Milieu 3 |
Aucune cellule lysée |
![]() Exploitez ces résultats et émettez une hypothèse quant à la manière dont se fait la reconnaissance des cellules infectées.
Exploitez ces résultats et émettez une hypothèse quant à la manière dont se fait la reconnaissance des cellules infectées.
2.1.2 Les récepteurs T:
Comme les lymphocytes B, les lymphocytes T naissent dans la moelle rouge des os, mais ils subissent leur maturation dans le Thymus: ceci signifie qu'ils y acquièrent leur immunocompétence, c'est-à-dire leur capacité à détecter des cellules anormales, présentant des marqueurs de surface différents de ceux des cellules normales de l'organisme. Cette reconnaissance est réalisée par la présence sur les lymphocytes T de récepteurs spécifiques appelés récepteurs T.
Parmi ces LT se trouvent des lymphocytes T8 (LT8) possédant des récepteurs CD8: préalablement sensibilisés à un antigène, ils attaquent toute cellule présentant à leur surface l'antigène contre lequel elles ont été sensibilisées. On les appelle lymphocytes T cytotoxiques (LTc).
 Comme nous l'avons fait dans le §1.2.2 à propos de la structure d'un anticorps on pourra trouver à l'adresse:
Comme nous l'avons fait dans le §1.2.2 à propos de la structure d'un anticorps on pourra trouver à l'adresse:
http://www.inrp.fr/Acces/biotic/immuno/html/demtcr.htm
toutes les ressources destinées à résoudre le problème biologique suivant, concernant le virus du SIDA:
Qu'est-ce qui, dans la structure d'un récepteur T, explique sa capacité à se lier spécifiquement au fragment peptidique issu des protéines du pathogène?
 Mais nous rappellerons ici les limites du programme: "... l'étude de la nature des récepteurs T et des mécanismes de présentation des peptides antigéniques par les cellules présentatrices de l'antigène n'est pas au programme. Le rôle du CMH est hors programme."
Mais nous rappellerons ici les limites du programme: "... l'étude de la nature des récepteurs T et des mécanismes de présentation des peptides antigéniques par les cellules présentatrices de l'antigène n'est pas au programme. Le rôle du CMH est hors programme."
Les récepteurs T sont des protéines membranaires constituées de deux chaînes peptidiques. Chaque chaîne possède, comme celle d'un anticorps, une partie constante et une partie variable.
Le modèle moléculaire simple d'un récepteur T peut être représenté comme sur le schéma ci-dessus.
2.2 ÉLIMINATION DES CELLULES ANORMALES
On peut résumer le "scénario" de l'attaque d'une cellule-cible de la façon suivante:
Contact entre LTc et cellule-cible,
Libération du contenu de certaines vésicules cytoplasmiques par le LTc,
Mort de la cellule quelques heures plus tard, que l'on peut schématiser très simplement selon deux mécanismes:
- l'apoptose, qui est un processus d'autodestruction cellulaire ("suicide cellulaire") programmé génétiquement, mais accéléré par certains signaux issus de l'environnement cellulaire: l'ADN se fragmente, la membrane bourgeonne.
- la cytolyse: la cellule infectée est l'objet d'une attaque par des protéines libérées par le lymphocyte cytotoxique, qui "percent" littéralement la membrane et font éclater la cellule.
Dans les deux cas, les fragments cellulaires seront phagocytés par des granulocytes et des macrophages.

![]() Comparez l'action des cellules "tueuses" à celle des anticorps.
Comparez l'action des cellules "tueuses" à celle des anticorps.
2.3 ORIGINE DES LYMPHOCYTES T
Comme nous l'avons précisé dans le §2.1.2, les lymphocytes T acquièrent leur immunocompétence dans le thymus: cela correspond en fait à la sélection de clones de LT reconnaissant des antigènes étrangers à l'organisme (ceux qui réagiraient au molécules du soi - résultats de l'expression du génome de l'individu - sont éliminés).
des lymphocytes T possédant des marqueurs CD8, appelés LT8,
des lymphocytes T possédant des marqueurs CD4, appelés LT4.
La reconnaissance de l'antigène se fait grâce à une immunoglobuline que l'on a appelée ci-dessus récepteur T.
 Différant des anticorps par la présence de deux chaînes polypeptidiques, au lieu de quatre, les récepteurs T présente aussi une partie variable conférant aux lymphocytes T une telle diversité qu'il existe des millions de clones différents de LT, constitués chacun de quelques milliers de cellules, capables de reconnaître le même antigène membranaire.
Différant des anticorps par la présence de deux chaînes polypeptidiques, au lieu de quatre, les récepteurs T présente aussi une partie variable conférant aux lymphocytes T une telle diversité qu'il existe des millions de clones différents de LT, constitués chacun de quelques milliers de cellules, capables de reconnaître le même antigène membranaire.
En résumé, les lymphocytes T, grâce à leurs récepteurs T, reconnaissent des antigènes présentés sur les membranes des cellules de l'organisme.
Comme pour les LB, l'activation des LT, à qui des cellules anormales banales ou des macrophages ont présenté un antigène, se fait selon les mêmes étapes (voyez le schéma ci-contre).
![]() Comparez les possibilités de reconnaissance des antigènes par les lymphocytes B et par les lymphocytes T.
Comparez les possibilités de reconnaissance des antigènes par les lymphocytes B et par les lymphocytes T.
3 Les lymphocytes T4, clé de voûte des réactions immunitaires spécifiques
3.1 UN EXEMPLE DE COOPERATION CELLULAIRE
 Des pneumocoques tués (PnT) non pathogènes sont injectés à une souris. Cinq jours après on prélève les leucocytes de la souris, qui sont répartis, comme l'indique le schéma, dans trois milieux de culture.
Des pneumocoques tués (PnT) non pathogènes sont injectés à une souris. Cinq jours après on prélève les leucocytes de la souris, qui sont répartis, comme l'indique le schéma, dans trois milieux de culture.
On ajoute des pneumocoques pathogènes (Pn) dans les trois milieux, puis huit jours après on prélève le surnageant (phase liquide) des trois milieux que l'on place dans les récipients 1,2 et 3. On y ajoute des pneumocoques pathogènes.
Dans les récipients 2 et 3 les pneumocoques ne sont pas agglutinés et donc gardent leur pouvoir pathogène; dans le récipient 1 ils sont agglutinés et perdent leur pouvoir pathogène.
![]() En sachant que l'agglutination résulte de la réaction antigène-anticorps, dans laquelle les anticorps provoquent l'assemblage en masse des cellules présentant les antigènes correspondants sur leur surface, étudiez les résultats de cette expérience; quelle hypothèse peut-on proposer pour les expliquer?
En sachant que l'agglutination résulte de la réaction antigène-anticorps, dans laquelle les anticorps provoquent l'assemblage en masse des cellules présentant les antigènes correspondants sur leur surface, étudiez les résultats de cette expérience; quelle hypothèse peut-on proposer pour les expliquer?
3.2 LIEN ENTRE LES DIFFERENTES REACTIONS IMMUNITAIRES SPECIFIQUES:
Les expériences de Claman (1966)
 Trois souris (2, 3 et 4) sont thymectomisées puis irradiées. On réalise ensuite une greffe de moelle osseuse (souris 2), de thymus (souris 3) ou des deux (souris 4) et on leur injecte des pneumocoques tués (PnT).
Trois souris (2, 3 et 4) sont thymectomisées puis irradiées. On réalise ensuite une greffe de moelle osseuse (souris 2), de thymus (souris 3) ou des deux (souris 4) et on leur injecte des pneumocoques tués (PnT).
La souris 1 permet de réaliser une expérience témoin.
Cinq jours après, le sérum de la souris 2 permet une très légère agglutination des Pneumocoques Pn.
Celui de la souris 3 ne permet aucune agglutination, celui de la souris 4 une agglutination nette.
![]() A la lumière de ce que vous connaissez des phénomènes qui ont lieu dans la moelle et le thymus, expliquez les résultats du document. Quelle précision supplémentaire apporte cette expérience concernant les mécanismes de coopération entre cellules immunitaires?
A la lumière de ce que vous connaissez des phénomènes qui ont lieu dans la moelle et le thymus, expliquez les résultats du document. Quelle précision supplémentaire apporte cette expérience concernant les mécanismes de coopération entre cellules immunitaires?
 On prépare cinq milieux de cultures à partir de cellules appartenant à une même souris qui a subi quelques jours auparavant une injection de PnT.
On prépare cinq milieux de cultures à partir de cellules appartenant à une même souris qui a subi quelques jours auparavant une injection de PnT.
Les cinq milieux de culture contiennent au départ des macrophages. Les lymphocytes B et T sont ajoutés ou non selon la culture. Toutes les cellules reçoivent des Pneumocoques vivants (Pn).
La culture 5 subit une opération particulière: après une heure environ, pendant laquelle macrophages et pneumocoques ont été réunis, le surnageant est vidé, le récipient est lavé (les macrophages restent adhérents à la paroi du récipient), un nouveau milieu nutritif est installé auquel on ajoute des lymphocytes B et T.
Quelques jours après on dose les immunoglobulines dans le surnageant des 5 milieux. Dans le document un diagramme regroupe les résultats de ces dosages.
![]() Etudiez les résultats. Dans quel but est réalisé le lavage du milieu de culture 5? Les résultats obtenus vous permettent-ils de poser une hypothèse quant à la capacité de communication cellulaire entre macrophages et lymphocytes?
Etudiez les résultats. Dans quel but est réalisé le lavage du milieu de culture 5? Les résultats obtenus vous permettent-ils de poser une hypothèse quant à la capacité de communication cellulaire entre macrophages et lymphocytes?
 3.3 LE RÔLE CENTRAL DES LT4
3.3 LE RÔLE CENTRAL DES LT4
Les cellules immunitaires ont la capacité de communiquer entre elles grâce à des signaux chimiques: il en est ainsi des macrophages et des lymphocytes qui sécrètent des glycoprotéines appelées interleukines (IL). Ces molécules, élaborées par des LT4 sécréteurs (LT4s) sont aptes à stimuler les cellules immuno-compétentes voisines.
Les clones de LB et de LT8 activés sont ainsi stimulés, ce qui favorise la prolifération de plasmocytes sécréteurs d'anticorps et de LTc. L'arsenal immunitaire acquis dépend ainsi de l'activité des LT4 qui jouent un rôle central dans les mécanismes de défense.
3.4 LES MECANISMES DE DESTRUCTION DES LT4 PAR LE VIH sont encore mal connus: il semblerait que la mort provoquée par la multiplication virale à l'intérieur des lymphocytes entre pour une faible part dans l'effondrement du taux sanguin de LT4 et que l'apoptose en serait la cause majeure.
Dans le cas du SIDA, la disparition des lymphocytes T4 empêche la production d'anticorps et de lymphocytes T cytotoxiques contre des agents microbiens variés. Ceci permet l'apparition de maladies opportunistes.
Les conséquences de l'effondrement des défenses immunitaires prouvent qu'en permanence les mécanismes immunitaires sont à l'oeuvre et montrent le rôle essentiel des lymphocytes T4 dans la majorité de ces réactions.

